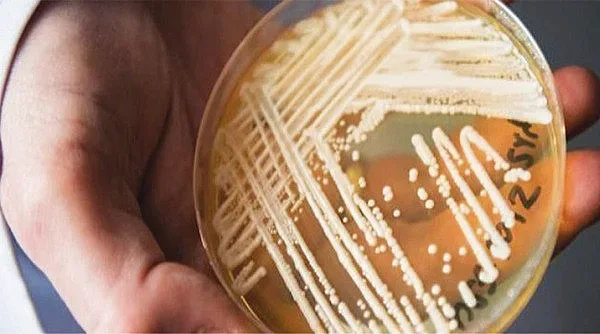
Открита в Япония гъбичка сее смърт в Европа и САЩ

„Ако вашата единствена цел е да станете богати, вие никога няма да я постигнете“. Казал го е милиардерът Джон Рокфелер. Тези слова звучат наистина много интересно, особено като се има предвид от чия уста са били произнесени. За мнозина парите винаги са били цел номер едно в живота, а основният довод, който е използван, за да се оправдае дивото им преследване е, че те са единственото нещо, което може да ти осигури спокойствие. Апропо – много погрешно схващане!
Истината е, че финикийските знаци не могат да ти осигурят нито спокойствие, нито щастие, независимо дали ги имаш или не.
И в двата случая тегне едно огромно притеснение и горчивина. При липсата им се терзаем как ще се оправим с битовите си нужди. При изобилието им пък се изяждаме от вътрешни дълбоки съмнения дали всички, които ни заобикалят не го правят заради облагата. Е, това ако е бленуваното щастие, здраве му кажи!
Някога в миналото Пабло Пикасо е казал нещо много интересно, което звучи така: „Искам да живея като беден човек с пари“! И върху тези думи човек си заслужава да поразсъждава. Що за „животно“ ще да е това? Вероятно художникът, усетил болезнената страна на славата и имането, е установил, че скромният човек, запазил своите духовни белези, определящи го за отделна идентичност, живее в пъти по-нормално.
Единственият недостатък на така нареченото духовно богатство е, че не може да ти плати сметките за тока, например. Така вероятно се е родила в съзнанието му безумната идея, спомената в предходните редове. Между другото тази мисъл изключително много подхожда на някои дами, които родна институция е взела на мушка. Защо ли? Защото те някак са успели да сбъднат иначе съкровеното желание на Пикасо – преживяват бедно, но с доста пари. Заключението по въпроса е направено на база крайният резултат, видим за простото око. Нулево количество работни дни, но пък за сметка на това доход, на който биха могли да завидят повече от половината български граждани, бъхтащи се по 12-13 часа, че и повече.
Ето така, между другото, се раждат и етикетите, които толкова много обичаме да лепим на хората за щяло и нещяло.
Заради пустата завист, че, видиш ли, някой е открил златната среда за своето съществуване, без да си дава зор, друг се чувства силно прекаран, че хем трябва да бачка като луд, хем не може и да си помисли да направи какъвто и да е кощунствен страничен разход. Естествено, вината я отнася имащият. Но, както казва роденият в Русия лекар и афорист Генадий Малкин: „Ако не бяха богаташите, богатството нямаше да дразни никого“! Само дето ние, българите, основно хейтим родните люде с милионите. Да не кажем, че и всеки, имащ пари, е сложен под голямата дебела черта – мошеник, заграбил парите на народа.
Нека напомним обаче, че не всичко на този свят е черно и бяло. Има и други цветове. Защо със същия хъс не вземем да нападнем някой тънещ в лукс, я в Америка, я в други европейски държави. Не го правим, защото носът ни пречи да виждаме по-надалеч от пределите на родината си. Поради същата тази причина и страдаме от други проблеми, далеч нямащи много общо с паричките.
Имаме предвид здравословните такива. Тук веднага ще изскочи някой, който смело да заяви, че здравето струва пари. Така е, и то много! Но до този момент се стига, когато сляпо вярваш, че няма причина да зарежеш „най-долното си качество винаги да гледаш да минеш тънко и да не си платиш справедливо за това, което получаваш“! Едно време, когато са върлували доста страшни заболявания с потресаващо висок процент на смъртност, да не би баба ви да се е лекувала с валута?
Присъствието или отсъствието на средства не са основателна причина да се превръщаме в ходеща зараза! Да не говорим, че към днешна дата ситуацията е коренно различна. Сами постоянно се сблъскваме с примери, които ни дават да разберем, че когато човек иска да се избави от сполетялата го напаст намира начин! Да, някои от тях не са особено приятни, но ситуациите, касаещи здравето ни, рядко пъти ни предоставят различни опции, измежду които да избираме.
Една такава, заслужаваща сериозно внимание, е темата за мултирезистентните патогенни микроорганизми. От много време насам световните здравни организации системно алармират за опасността от възникването на инфекции, резултат от "мутиралите инквизитори". Дори в едно от много проучвания, посветени на болезнената тема, се казва, че към 2050 година въпросните ще убиват повече хора, отколкото ракът, определен за бича на 21 век.
Тук смело можем да кажем, че в лицето на новопоявилите се бактерии, гъбички, паразити канцерогенният убиец има сериозна конкуренция.
До колко обаче ние осъзнаваме сериозната заплаха, пред която сме изправени? Можем да посочим редица патогени, способни да предизвикат или поне да повлекат след себе си толкова сериозни диагнози, колкото и не можем да си представим. По-лошото е, че се оказваме напълно неподготвени за борбата с тях.
Такъв е случаят с гъбичката Candida auris, определяна като новата глобална заплаха за здравето. Тя причинява фатални инвазивни инфекции, които не реагират на обичайните лечения.
Първоначално е идентифицирана в Япония през 2009 г., след това започва да се появява в САЩ и други държави в Европа. Освен третирането на инфекцията, причинена от патогена, доста сложно се оказва и самото й идентифициране, а от там и диагностициране. Candida auris обикновено се разпространява при индивиди, които вече имат сериозно заболяване или нарушена имунна система. Статистиката показва, че в рамките на 30-60% от хората, които са имали инфекции с Candida auris, са починали. Също така се посочва, че и много от тях са изложени на повишен риск от развитие на други сериозни заболявания.
По принцип хората могат без да подозират да „притежават“ гъбички в тялото си, най-вече по кожата, много преди да развият инфекция или да почувстват каквито и да е симптоми. Това състояние е известно като колонизация. Именно тези индивиди се явяват разпространители на патогена и съответно на болестта, предизвикана от него.
Симптомите при C. auris са разнообразни, но най-често срещаните са треска и студени тръпки. Те не се повлияват от антибиотично лечение! В тези случаи са необходими специализирани лабораторни тестове, за да се установи първо дали симптоматиката се дължи на инвазия с Candida auris.
Продължителното й присъствие в човешкия организъм често причинява инфекция в кръвния поток, ушите или в открити рани. Candida auris е един от малкото видове Candida, които могат да причинят кандидоза при хората. Тя може да предизвика инвазивна кандидоза (нахлуване на патогена в кръвта - фунгемия) при централната нервна система, бъбреците, черния дроб, костите, мускулите, ставите, далака или очите. Обикновено се проявява заедно с други съпътстващи диагнози като диабет, белодробни и бъбречни заболявания.
Лечението е сложно, тъй като гъбичката лесно се бърка с други представители от големия род на Candida. Също така клиниката не рядко се усложнява и от взаимодействието между микотичния агент и другите болестотворни микроорганизми, като бактерии и паразити.
Една много често срещана комбинация например е тази на Candida auris и Pseudomonas aeruginosa. Бактерията също е мултирезистентна и води до генерализирано възпаление при белите дробове, пикочните пътища и бъбреците. Проблемът е, че при наличието и на двете трудно може да се разбере кое всъщност е водещото при появилата се клиника.
Друга тежка комбинация е тази със Salmonella spp. Комплицираността тук идва от свойството на салмонелата да се капсулира в тялото. Това позволява на гъбичката да използва токсините на салмонелата, като по този начин я прави невидима. Именно гореспоменатите факти дават основание да се направи заключението, че най-трудното при лечението на едно заболяване е откриването на симбиозта между различните по рода си микроорганизми.
Но все пак нека не забравяме, че: „Срещата на два характера е като взаимодействието между две химически вещества: ако има реакция и двете се трансформират“ - Карл Юнг.
Последвайте ни в Google News Showcase за важните новини
Вижте всички актуални новини от Standartnews.com